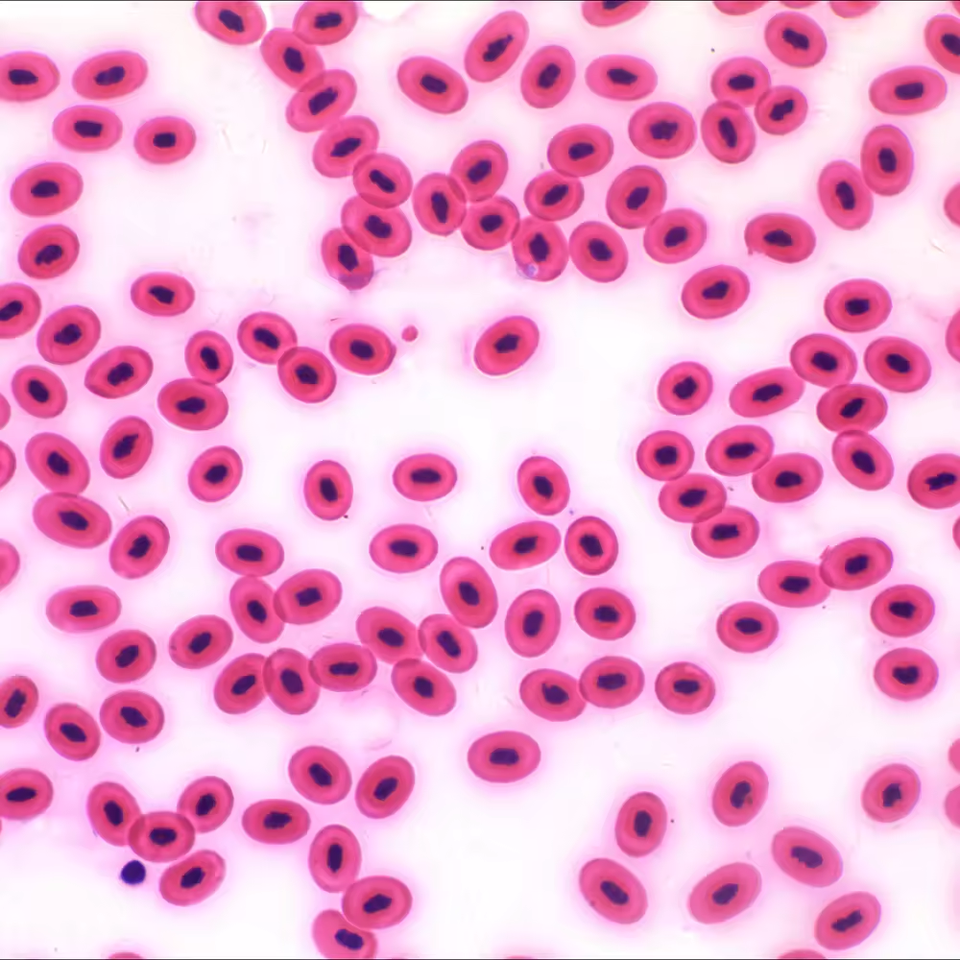

Microscope fluorescent trinoculaire LED de haute qualité BestScoep BS-2047FT pour laboratoire, meilleur prix
Note de la boutique :4.9
(28 avis)

Attributs
Microscope à fluorescenceType
Mise au point manuelleType de foyer
± 5DAjustement dioptrique
AutreRésolution de la caméra
NonAppui externe d'affichage
Ip65Indice de protection
Garantie commerciale:3 ans
Support personnalisé:OEM, ODM
Lieu dorigine:Beijing, China
Numéro de modèle:BS-2047FT
Nom de marque:BestScope
Système optique:Système optique à correction de couleur infinie
Tête de visualisation:Trinoculaire
Objectif:10 fois, 20 fois, 40 fois, 100 fois
Condenseur:N.A.Condenseur d'illuminateur Koehler 1.25
Éclairage:LED 3W
Oculaire:PL10X/22 mm
Porte-nez:Porte-objectif quintuple
Scène:Étage de peinture céramique mécanique à double couche
Module fluorescent à LED:Filtre passe-bande B1
Concentration:Système de mise au point coaxiale grossière et fine à main basse
Caractéristiques du produit
Type
Microscope à fluorescence
Type de foyer
Mise au point manuelle
Ajustement dioptrique
± 5D
Résolution de la caméra
Autre
Appui externe d'affichage
Non
Indice de protection
Ip65
Garantie commerciale
3 ans
Support personnalisé
OEM, ODM
Lieu dorigine
Beijing, China
Numéro de modèle
BS-2047FT
Nom de marque
BestScope
Système optique
Système optique à correction de couleur infinie
Tête de visualisation
Trinoculaire
Objectif
10 fois, 20 fois, 40 fois, 100 fois
Condenseur
N.A.Condenseur d'illuminateur Koehler 1.25
Éclairage
LED 3W
Oculaire
PL10X/22 mm
Porte-nez
Porte-objectif quintuple
Scène
Étage de peinture céramique mécanique à double couche
Module fluorescent à LED
Filtre passe-bande B1
Concentration
Système de mise au point coaxiale grossière et fine à main basse
Emballage et livraison
vente Unités
Article unique
seul paquet taille
60X58X53 cm
unique poids brut
9.000 kg
Délai de préparation de la commande
Description des produits par le fournisseur
Avertissement/Disclaimer
Ce produit a acquis la (les) qualification(s) de produit/licence (s) pertinente (s) de certains pays applicables.Voir plus
Quantité minimale : 1 jeu
2 303,94 €
Options
SélectionnerGrossissement de loculaire: 10x
10x
Grossissement: 1000x
1000x
100 X
400x
40x
Grossissement de lobjectif
40x
10x
100x
4x
Capacité de personnalisation du fournisseur
Personnalisation simple
Personnalisation à partir de modèles
Personnalisation à partir d’échantillons
Personnalisation complète
Expédition
Frais de livraison et date de livraison à négocier. Contactez le fournisseur dès maintenant pour plus d’informations.
Payez en 4X sans frais avec
Protection des commandes Alibaba.com
Paiements sécurisés
Chaque paiement que vous effectuez sur Alibaba.com est sécurisé par un cryptage SSL strict et des protocoles de protection des données PCI DSS.
Retour facile
Effectuez des retours locaux gratuits pour les défauts sur les achats éligibles
Protection de remboursement
Demandez un remboursement si votre commande n'est pas expédiée, est introuvable ou arrive avec des problèmes liés au produit














